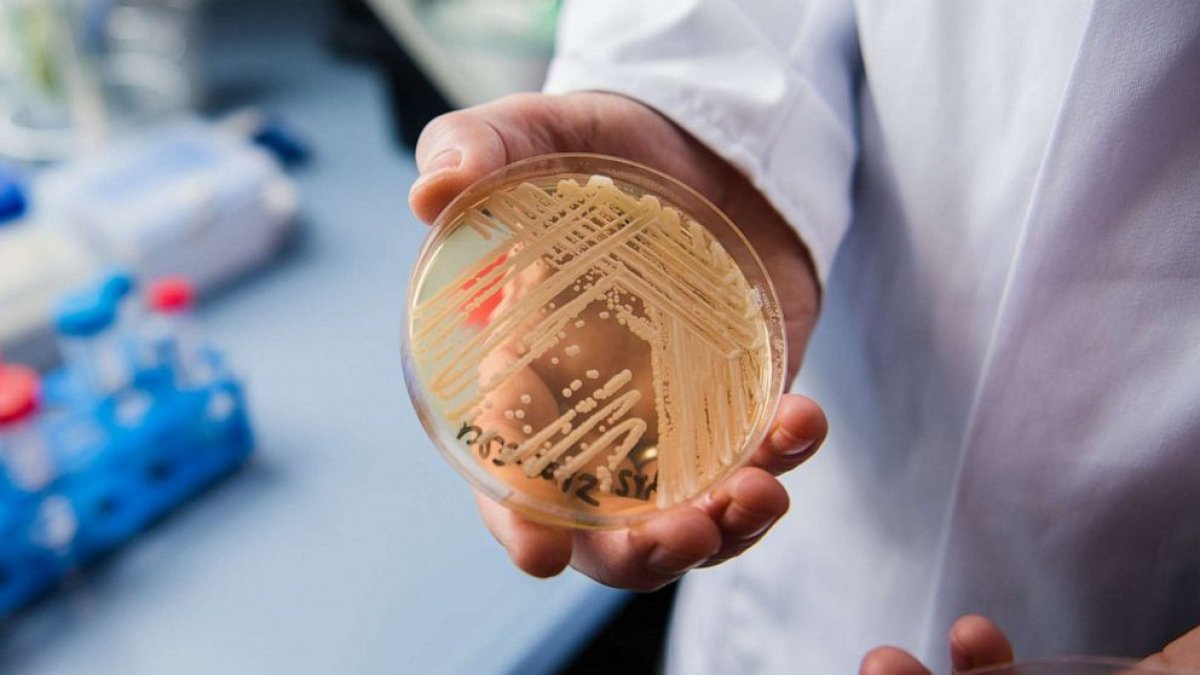
El director del Centro Nacional de Referencia para Infecciones Invasivas por Hongos, Oliver Kurzai, sostiene una placa de Petri que contiene la levadura 'Candida auris'.

Alarma internacional por mortal hongo que se propaga por Estados Unidos
Así como en la serie de 'The Last of Us', Los norteamericanos conviven con una "amenaza urgente", que suele causar la muerte en tan solo 90 días.
El director del Centro Nacional de Referencia para Infecciones Invasivas por Hongos, Oliver Kurzai, sostiene una placa de Petri que contiene la levadura 'Candida auris'.
'The last of Us' parece ser una predicción de la vida real y justo en pleno éxito de la serie en Estado Unidos. El aumento de casos por 'Candida auris', ha alertado y atemorizado a todos, ya que aún quedan las secuelas haber vivido una pandemia por Covid-19 en 2020. Incluso la OMS considera que se trataría de una “amenaza urgente” ya que a menudo es resistente a múltiples medicamentos.
Considerado potencialmente mortal, este microorganismo ya se encuentra presente en más de la mitad de los estados norteamericanos. Investigadores creen en un aumento de los casos que son resistentes a las equinocandinas, el principal fármaco que se utiliza para tratar las infecciones con el hongo Candida.
El hongo, Candida auris, es una especie de levadura que no suele ser dañina en personas sanas, pero puede representar un riesgo mortal para pacientes delicados en hospitales y asilos de ancianos. Se propaga fácilmente, ya que puede causar infecciones en heridas, oídos y en el flujo sanguíneo. Algunas cepas son las llamadas superbacterias que son resistentes a los tres tipos de antibióticos usados para tratar infecciones micóticas. También resistente a algunos desinfectantes comunes y se puede estar en la piel de las personas sin causar síntomas.
Fue identificó por primera vez en Japón en 2009 y cada vez se ve más en otros países. El primer caso en Estados Unidos fue en 2013, pero no se reportó hasta 2016. Ese año, funcionarios de salud estadounidenses reportaron 53 casos.